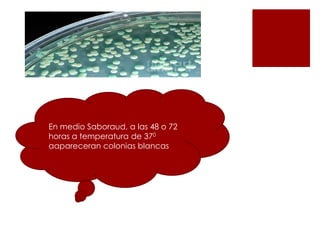
En medio Saboraud, a las 48 o 72
horas a temperatura de 370
aapareceran colonias blancas

La candidiasis fue descrita por primera vez en 1923. Es causada por hongos del género Candida, especialmente C. albicans. Puede presentarse en la piel, boca, tracto gastrointestinal y vagina. Los factores de riesgo incluyen diabetes, uso de anticonceptivos y embarazo. Los síntomas incluyen prurito, eritema y flujo vaginal. El tratamiento depende de la gravedad e incluye antifúngicos tópicos y orales como nistatina, clotrimazol y fluconazol.